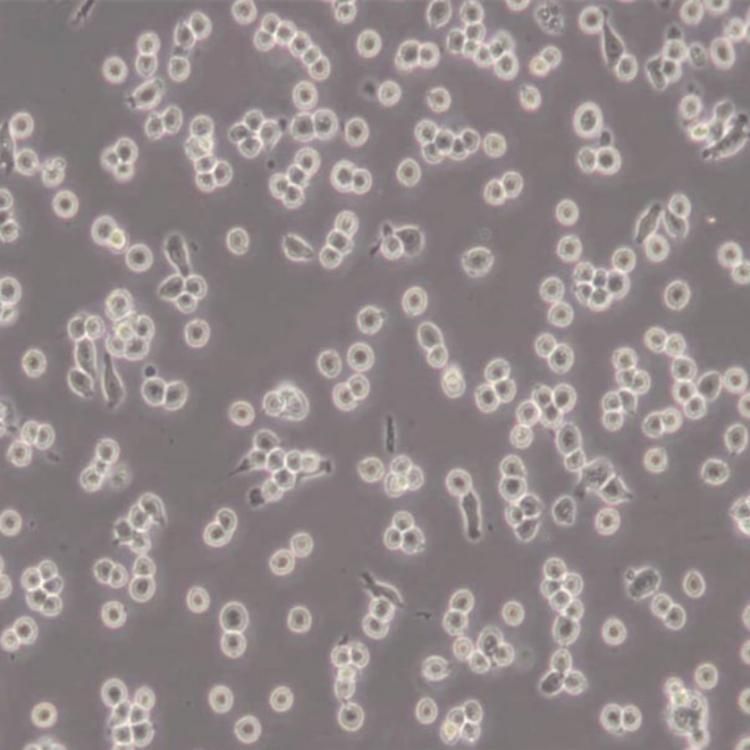
产品封面图

万千商家帮你免费找货
0 人在求购买到急需产品
- 详细信息
- 文献和实验
- 技术资料
- 库存:
大量
- 供应商:
上海酶联生物科技有限公司
- 英文名:
B16-F10细胞
- 规格:
1*125ml/500ml
| 规格: | 1*125ml | 产品价格: | ¥360.0 |
|---|---|---|---|
| 规格: | 500ml | 产品价格: | ¥1080.0 |

B16-F10 细胞专用培养基
产品介绍
B16-F10细胞专用培养基由mlBio/酶联生物团队精心优化,经过长期测试,本产品可保持B16-F10细胞佳的生长状态。
本产品中已包含 B16-F10 细胞生长所需的各种成分,无需添加任何成分,可直接用于B16-F10 细胞的培养。
产品主要成分
| DMEM(含NaHCO3 1.5g / L)基础培 | 445ml |
| 特级胎牛血清 | 50 ml |
| P/S青霉素-链霉素 | 5 ml |
运输和保存
运输:放置于含有生物冰袋的保温箱中低温运输
保存方法:2℃~8℃,避光,保存2个月;-20℃,避光,保存6个月。
质量控制
| 检测项目 | 质量控制 | |
| 澄清度 | 澄清 | |
| PH | 7.3±0.2 | |
| 内毒素含量 (EU/mL) | ≤10 | |
| 无菌检测 | 细菌 | 阴性 |
| 真菌 | 阴性 | |
| 支原体 | 阴性 | |
| 细胞生长试验 | 细胞形态 | 正常 |
| 细胞生长实验 | 合格 | |
B16-F10 细胞专用培养基注意事项
1、收到产品请先检查包装是否完,如有破损,漏液、浑浊等现象请及时联系我们,培养基冻融后,可能会有少量絮状物析出,不影响产品正常使用。
2、请仔细阅读产品说明书,了解产品使用方法、保存方式、有效期等信息,若因操作失误,保存不当而导致产品出现污染等问题的,责任由客户自行承担。
3、本产品仅能用于科研,培养基中的一些组分对人体有较低的危害性,如有接触立即用大量清水冲洗即可。
风险提示:丁香通仅作为第三方平台,为商家信息发布提供平台空间。用户咨询产品时请注意保护个人信息及财产安全,合理判断,谨慎选购商品,商家和用户对交易行为负责。对于医疗器械类产品,请先查证核实企业经营资质和医疗器械产品注册证情况。
文献和实验相关实验
树突状细胞培养操作步骤 准备补充剂 将补充剂混合物在 15~25℃ 解冻。在无菌条件下用移液枪小心地将补充剂混合物混匀。然后,把补充剂混合物全部加到基础培养基中。盖上瓶子,轻轻混匀直到形成均一的混合物。DC生成培养基所附带的相应的细胞因子组合包含有成分A和B,它们都是以100X 的原液状态运输的。 注意:此时不要将化合物B加入培养基中。 DC基础培养基不带细胞因子,因此使用时必须另外自行添加。 新鲜分离的单核 DC 细胞的传代 对于新鲜分离自外
细胞培养的基本步骤都有哪些?复苏、传代、冻存的基本操作是什么样的?如果你刚刚开始细胞培养实验,想要建立稳定的细胞培养流程,快来听Dr. 赛的讲解吧。
PromoCell MSC分化培养操作步骤 一、向神经细胞分化的操作流程 1、将塑料培养器用纤维连接蛋白包被根据操作手册,用纤维连接蛋白(C-43050)包被合适的组织培养瓶。使用浓度为10μg/ml。2、接种间充质干细胞用MSC生长培养基(C-28010)在用纤维连接蛋白包被过的培养瓶中接种培养,接种密度为4000个/cm2。3、培养间充质干细胞将细胞培养至80%的饱和度,每48小时更换一次培养基。4、诱导间充质干细胞用MSCU经细胞分化培养基(C-28015)诱导培养,用MSC
技术资料B16-F10 细胞专用培养基
¥360 - 1080